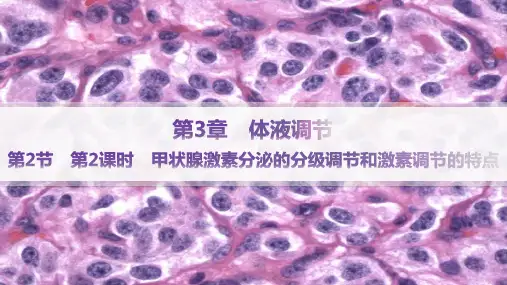

对点应用•突破 突破点1 激素调节的特点 3.下列对动物激素调节特点的叙述,正确的是( B ) A.激素是细胞的组成成分,种类多、含量极微 B.激素发挥作用后即失活 C.激素分子弥散在体液中,对全身细胞都起作用 D.健康人体内的激素含量是恒定不变的
解析 激素只能起调节作用,不是细胞的组成成分,A项错误;激素与靶细胞 结合并发挥作用后就失活,B项正确;激素分子弥散在体液中,随体液运往全 身,但只对特定的靶器官、靶细胞起作用,C项错误;人体内的激素含量不是 恒定不变的,会随内环境的变化而变化,D项错误。
(3)意义:分级调节可以放大激素的调节效应,形成多级反馈调节,有利于精
细调控,从而 维持机体的稳态
。
结论语句 辨一辨 (1)血液中甲状腺激素水平降低会使促甲状腺激素释放激素的分泌减少。
( ×) (2)垂体不但能分泌促甲状腺激素释放激素,而且能分泌生长激素。( × ) (3)所有的反馈调节都会使相关过程趋于平衡。( × )
A.甲状腺激素作用的靶细胞是下丘脑和垂体细胞 B.甲状腺激素分泌过程中存在分级调节和反馈调节 C.寒冷刺激时,TRH分泌增多,TSH分泌减少 D.甲状腺激素含量增加到一定程度时,过程①起促进作用,过程②起抑制作 用
解析 甲状腺激素作用的靶细胞是几乎全身所有的细胞,A项错误;寒冷刺激 时,TRH分泌增多,会促进垂体分泌TSH增多,进而使甲状腺分泌甲状腺激 素增多,C项错误;甲状腺激素含量增加到一定程度时,过程①和过程②都起 抑制作用,D项错误。
情境探究•提升 如图为人体分泌细胞分泌的激素作用于靶细胞的两种机理示意图,结合教 材回答下列问题。
(1)从上图可以看出内分泌腺没有 导管 ,其分泌的激素弥散到 体液 中, 随血液流到 全身 ,不会定向运输到靶器官、靶细胞。 (2)激素的作用方式是将信息从 内分泌细胞 传递给 靶细胞 , 改变其原有的生理活动。激素本身既不组成 细胞结构 ,又不提供